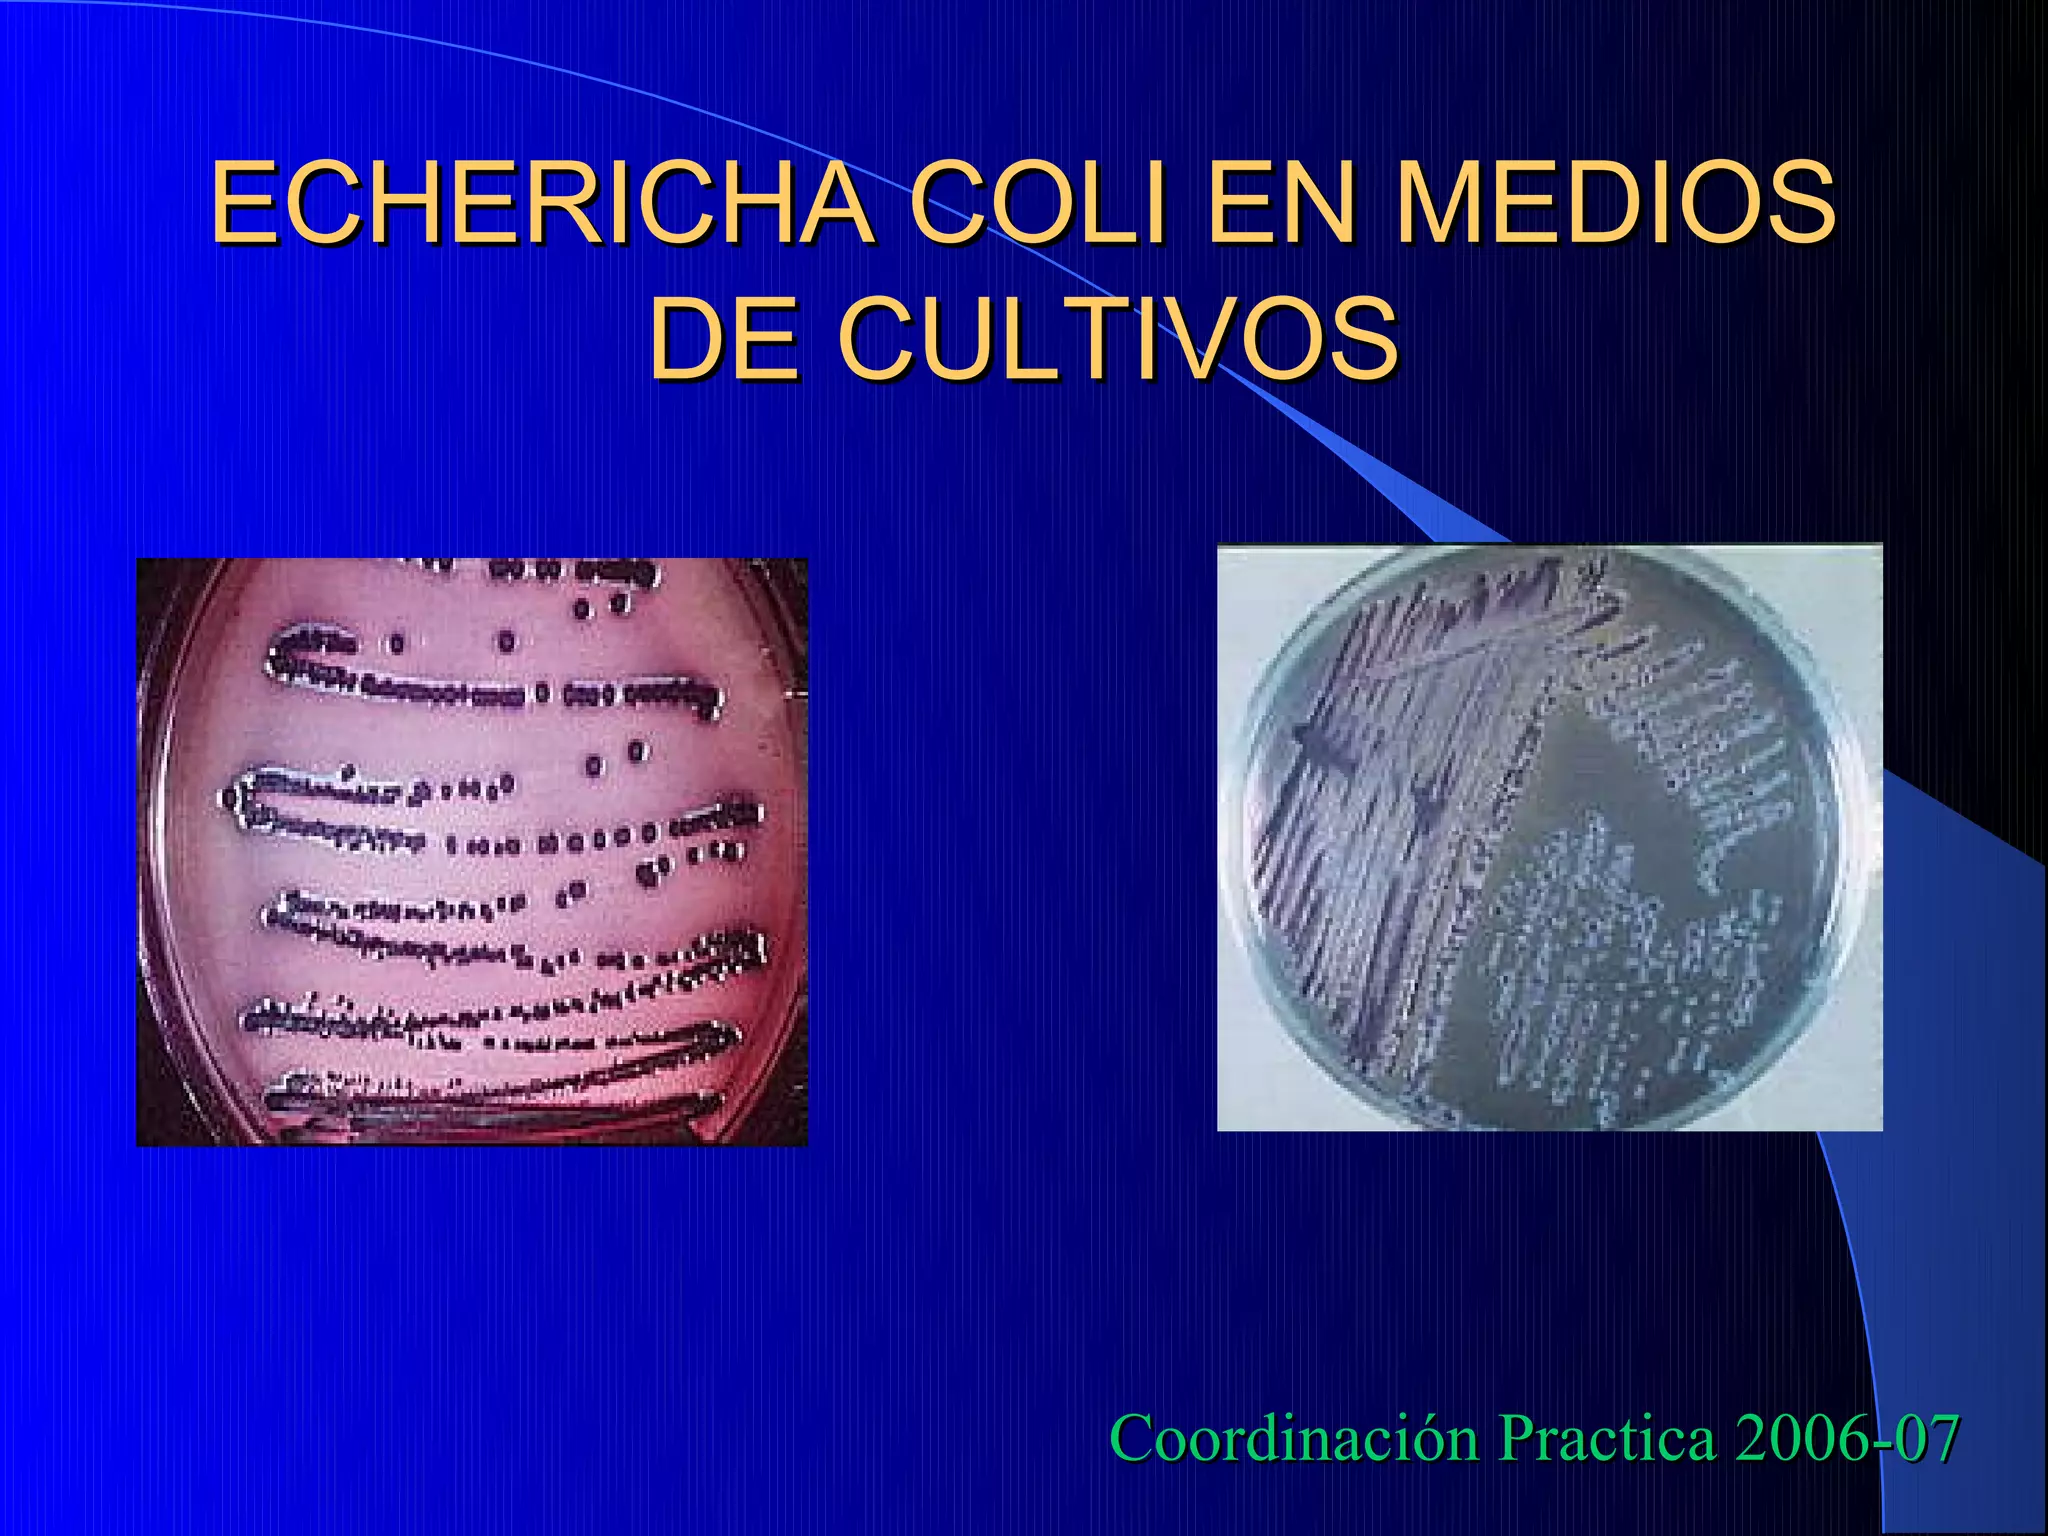
ECHERICHA COLI EN MEDIOS
      DE CULTIVOS




             Coordinación Practica 2006-07

La familia Enterobacteriaceae incluye bacterias gramnegativas como Escherichia, Citrobacter, Enterobacter, Shigella, Providencia y Serratia. Son bacilos no esporulados que pueden ser móviles y crecen en presencia o ausencia de oxígeno. Incluyen patógenos importantes que causan infecciones como la fiebre tifoidea, cólera y diarrea.